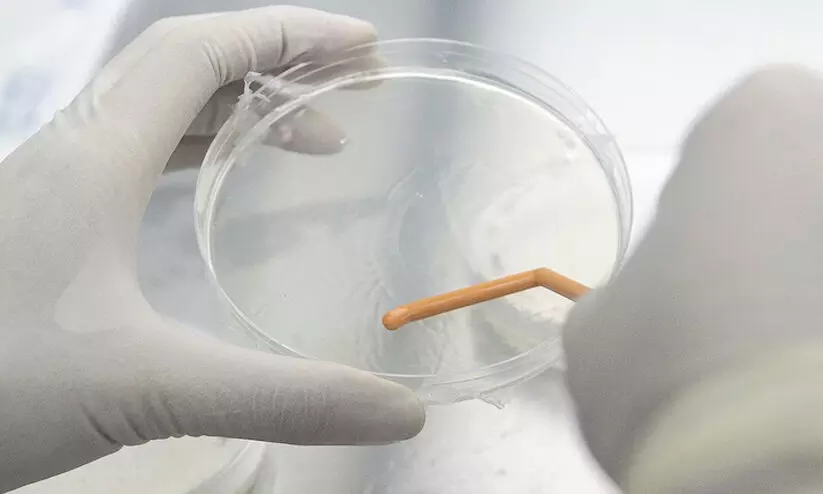

രാജ്യത്തെ രണ്ടാമത്തെ എച്ച്.എം.പി.വി കേസും സ്ഥിരീകരിച്ചു
text_fieldsന്യൂഡൽഹി: ചൈനയിൽ വ്യാപകമായി പടരുന്ന ഹ്യൂമൻ മെറ്റന്യൂമോവൈറസ് (എച്ച്.എം.പി.വി) കേസ് രാജ്യത്ത് ആദ്യമായി സ്ഥിരീകരിച്ചതിന് പിന്നാലെ രണ്ടാമത്തെ കേസും കണ്ടെത്തി. ബംഗളൂരുവിൽ എട്ടുമാസം പ്രായമുള്ള ആൺകുഞ്ഞിനായിരുന്നു വൈറസ് ബാധ ആദ്യം സ്ഥിരീകരിച്ചത്. ബംഗളൂരുവിൽ സ്വകാര്യ ആശുപത്രിയിൽ ചികിത്സയിലുള്ള എട്ടു മാസം പ്രായമുള്ള ആൺകുഞ്ഞിനാണ് ഇപ്പോൾ വൈറസ് ബാധ സ്ഥിരീകരിച്ചത്. കടുത്ത പനിയും ജദലദോഷവും അനുഭവപ്പെട്ടതിനെ തുടർന്നാണ് കുഞ്ഞിനെ ആശുപത്രിയിൽ പ്രവേശിപ്പിച്ചത്. കുട്ടിയുടെ നില ഗുരുതരമല്ല. പിന്നാലെ കർണാടകയിൽ മറ്റൊരു കുഞ്ഞിനും വൈറസ് ബാധ കണ്ടെത്തുകയായിരുന്നു. രണ്ടാമത്തെ കേസിന്റെ വിശദാംശങ്ങൾ പുറത്തുവിട്ടിട്ടില്ല.
രണ്ടു കേസ് കണ്ടെത്തിയതായി കേന്ദ്ര ആരോഗ്യമന്ത്രാലയവും അറിയിച്ചു. ഇന്ത്യന് കൗണ്സില് ഓഫ് മെഡിക്കല് റിസര്ച്ചിന്റെ (ഐസിഎംആര്) പതിവ് നിരീക്ഷണത്തിലാണ് എച്ച്.എം.പി.വി കേസുകള് തിരിച്ചറിഞ്ഞതെന്നും ആരോഗ്യ മന്ത്രാലയം അറിയിച്ചു. രോഗത്തിന്റെ ഉറവിടം സംബന്ധിച്ച് പരിശോധിക്കുകയാണെന്ന് കർണാടക ആരോഗ്യ വകുപ്പ് അറിയിച്ചു.
എച്ച്.എം.പി.വി പ്രതിരോധിക്കാൻ ഇന്ത്യ സുസജ്ജമെന്ന് കഴിഞ്ഞ ദിവസം കേന്ദ്ര ആരോഗ്യ മന്ത്രാലയം വ്യക്തമാക്കിയിരുന്നു. സ്ഥിതിഗതികൾ വിലയിരുത്താൻ ആരോഗ്യ മന്ത്രാലയത്തിന്റെ മേൽനോട്ടത്തിൽ ചേർന്ന സംയുക്ത മോണിറ്ററിങ് ഗ്രൂപ്പ് യോഗം ചേർന്നിരുന്നു. എച്ച്.എം.പി.വി കേസുകളിൽ ആശങ്കപ്പെടേണ്ട സാഹചര്യമില്ലെന്ന് നാഷനൽ സെന്റർ ഫോർ ഡിസീസ് കൺട്രോൾ അറിയിക്കുന്നത്.
എച്ച്.എം.പി.വി വൈറസ്
ന്യൂമോവിരിഡേ കുടുംബത്തിലെ മെറ്റാന്യൂമോ വര്ഗത്തില്പെട്ട വൈറസാണിത്. ശ്വാസകോശ അണുബാധയുള്ള കുട്ടികളില് നിന്നുള്ള സാമ്പിളുകള് പഠിക്കുന്നതിനിടെ 2001ല് ഡച്ച് ഗവേഷകർ ആദ്യമായി കണ്ടെത്തി. പ്രായമായവരും കുട്ടികളും പ്രതിരോധശക്തി കുറഞ്ഞവരുമാണ് അപകടസാധ്യതാ വിഭാഗത്തിലുള്ളത്.
ശ്വാസകോശത്തെ ബാധിക്കുന്ന മറ്റ് രോഗങ്ങൾക്ക് സമാന ലക്ഷണം തന്നെയാണ് എച്ച്.എം.പി.വി ബാധിച്ചവർക്കും ഉണ്ടാകുക. ഫ്ലൂ ആയോ ചുമ, ജലദോഷം, പനി, തുമ്മൽ എന്നിങ്ങനെയോ ശരീരത്തിൽ കയറുന്ന വൈറസ്, രോഗപ്രതിരോധശേഷി കുറവുള്ളവരിൽ പിന്നീട് ബ്രോങ്കൈറ്റിസ്, ന്യുമോണിയ എന്നിവയിലേക്കു കടക്കും. കുട്ടികളിലും പ്രായമേറിയവരിലും വൈറസ് ബാധിച്ചാൽ തീവ്രമായ പനി ഉണ്ടാകും.
വൈറസിനെ പ്രതിരോധിക്കാൻ പ്രാപ്തമായ വാക്സിൻ കണ്ടെത്തിയിട്ടില്ലാത്തതും ആന്റിവൈറൽ മരുന്നുകൾ ഇല്ലാത്തതുമാണ് പ്രാധാന വെല്ലുവിളി. രോഗം വർധിക്കുന്നതിൽ കോവിഡിന് ശേഷമുള്ള ശാരീരിക അവസ്ഥയും തണുപ്പും പ്രധാന ഘടകമാണ്.
Don't miss the exclusive news, Stay updated
Subscribe to our Newsletter
By subscribing you agree to our Terms & Conditions.